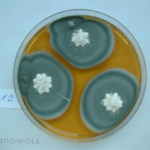

Schimmelpilze – Unsichtbar ungesund
Schimmelpilze sind überall
Der Grossteil der Pilze oder Bakterien (in feuchtem Baumaterial häufig festzustellen) schadet im Verborgenen, macht aber meist durch schlechten Geruch auf einen mikrobiellen Befall aufmerksam. Zudem kann vermehrtes Auftreten von Insekten, insbesondere Silberfischchen oder Staubläusen, ein Hinweis sein. Auch bei plötzlich auftretenden Gesundheitsproblemen, insbesondere der Atemwege oder der Haut oder bei rheumatischen Beschwerden, ist schnelles Handeln erforderlich. Das bedeutet: Experten heranzuziehen, die den potenziellen Schimmelschaden genau analysieren und seine Ursachen ermitteln können.
Sporen und Hyphen, die Grundstrukturen der Pilze, umgeben uns überall und in riesigen Mengen: zwischen 103 und 106 in jedem Kubikmeter. Durch Temperaturveränderungen kann man ihnen im Alltag wenig anhaben, denn sie überleben zwischen 0°C und 50°C. Auch der Einsatz chemischer Mittel erweist sich nur als kurzfristig wirksame Lösung. Chlorhaltige oder -freie Fungizide oder biologische Mittel wie z. B. Brennspiritus erzielen zwar kurzfristig die gewünschten Erfolge; ein dauerhafter Schutz ist dadurch allerdings nicht gegeben. Ausserdem sind humantoxische Folgen auch bei zugelassenen chemischen Produkten ganz und gar nicht auszuschliessen. Radikal, gründlich, aber ebenfalls keine endgültige Lösung: Das Abflammen per Bunsenbrenner oder der mechanische Abtrag des Untergrundes.
Im Garten, bei Nahrungsmitteln, an alten Kleidern und Schuhen, an Tapeten: Menschen kommen immer wieder mit Schimmelpilzen in Berührung – obwohl sie das schon von Natur aus nicht mögen. Bei der Wahrnehmung verschimmelter Nahrung und modriger Gerüche signalisiert der Körper Abwehrreaktionen, die ihn vor Krankheiten und Giften warnen. Zu recht, denn Pilze verderben nicht nur Innenräume und Textilien. Ganze fünf Prozent der Erntegüter weltweit fallen ihnen zum Opfer. Ausserdem lösen sie vor allem bei abwehrgeschwächten Menschen schwerste Erkrankungen aus.
Schimmelpilze – eine heterogene Gruppe
Genau genommen sind „Schimmelpilze“ eine Sammelbezeichnung für eine Vielzahl unterschiedlicher Pilzarten. Es existieren rund 100’000 erfasste Arten, mit entsprechend verschiedenen Erscheinungs- und Lebensformen. Ihre wichtigsten ökologischen und morphologischen Charakteristika sind:
- Ihr Lebensraum ist der Boden oder konzentrierte Nährlösungen.
- Schimmelpilze haben als Erstbesiedler eines Substrats nur wenige Konkurrenten.
- Sie gewinnen ihre Nährstoffe aus abgestorbenen organischen Substanzen, die sie dabei zersetzen.
- Schimmelpilze vermehren sich überwiegend ungeschlechtlich durch Sporen, von denen sie sehr rasch sehr grosse Mengen bilden, um dann möglichst schnell wieder neue Substrate zu besiedeln.
- Sie gedeihen in einem weiten Spektrum an Substraten und weltweit in allen Klimazonen.
In den meisten Böden finden Pilze also gute Lebensbedingungen, und das hat auch seine guten Seiten: Zur Erhaltung der Bodenfruchtbarkeit leisten sie in der Natur einen unverzichtbaren Beitrag, denn durch die gründliche Zersetzung organischer und anorganischer Verbindungen fördern sie die notwendige Rezyklierung. Gerade diese „destruktiven“ Fähigkeiten richten allerdings im menschlichen Umfeld viel Schaden an.
» Mehr über gesundheitliche Probleme, die durch Schimmelpilze verursacht werden, erfahren Sie im Blog „Schimmelpilze – eine Gesundheitsgefährdung„.
» Über Schäden, die der echte Hausschwamm anrichten kann, berichten wir im Blog „Hausschwamm – eine Gefahr für das Gebäude„.
» Wikipedia über Schimmelpilze

I like this site very much, It’s a really nice post to read and good information. Bettye Galloway